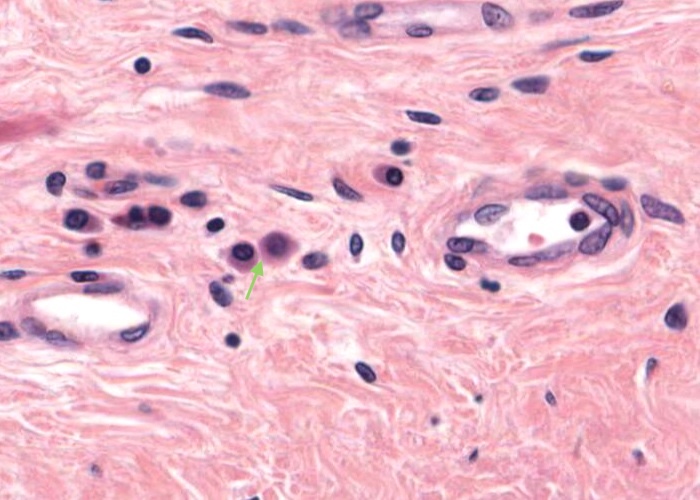
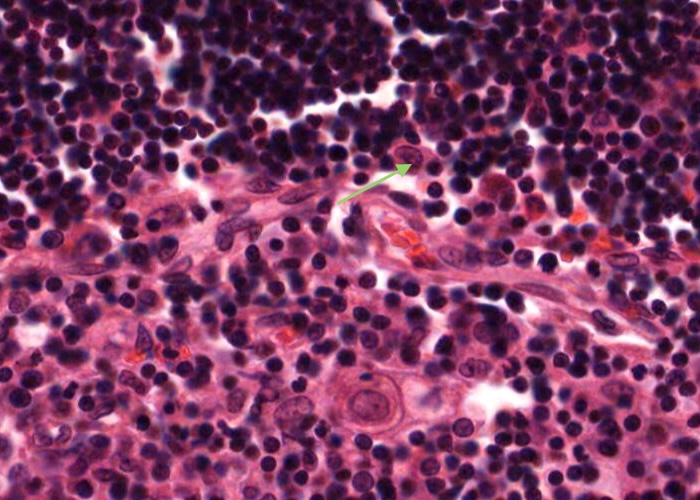
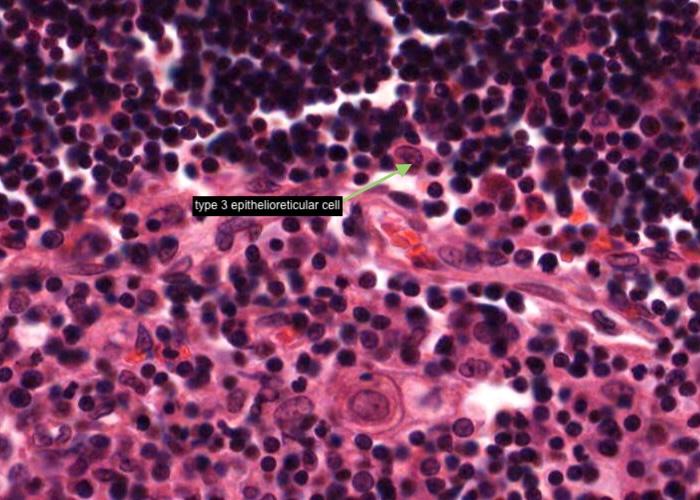
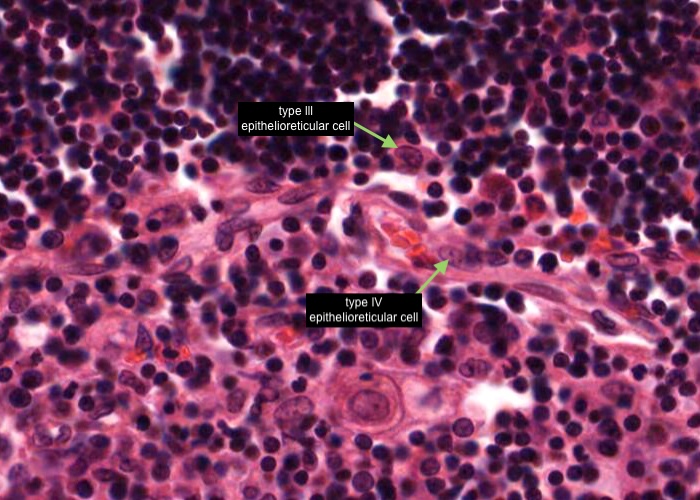
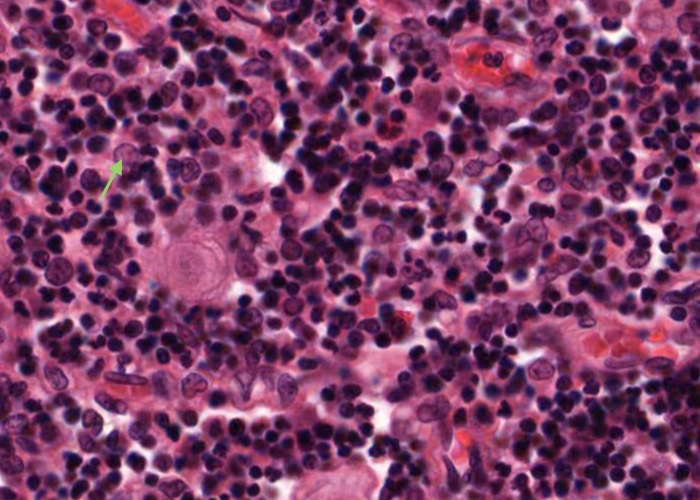
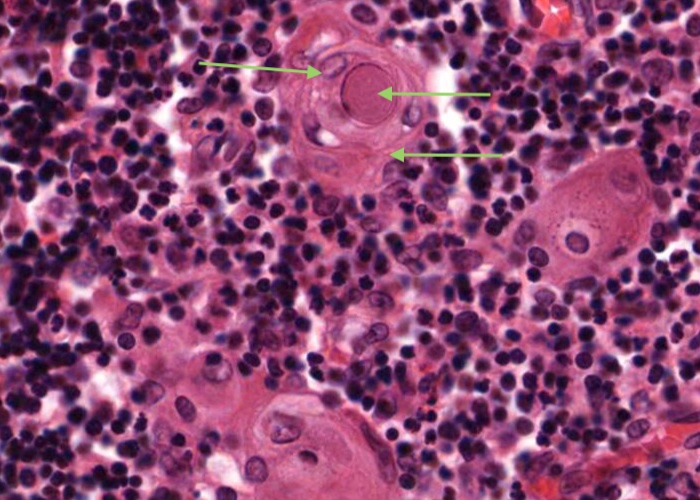
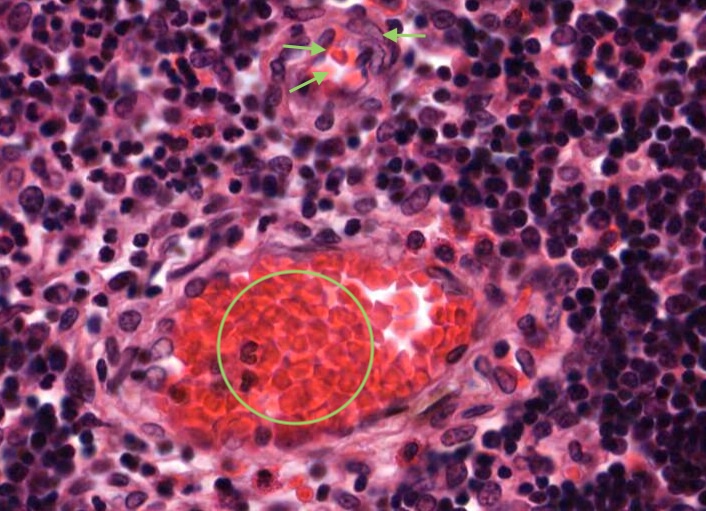
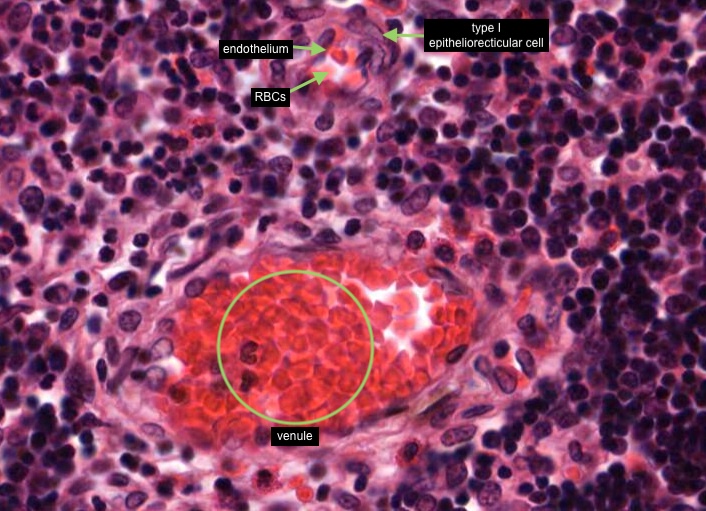
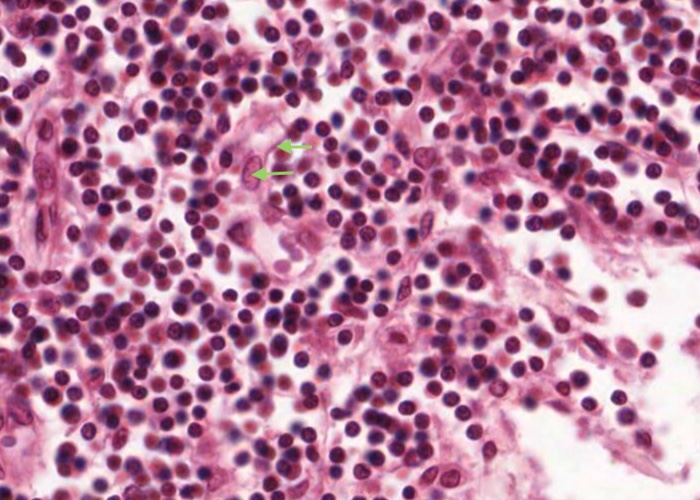
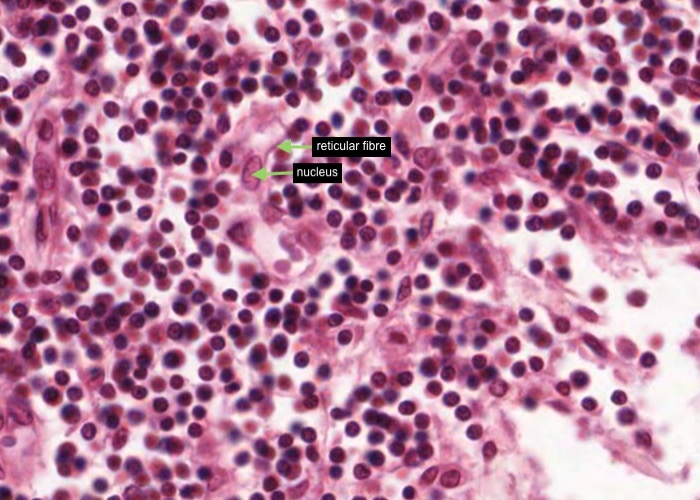
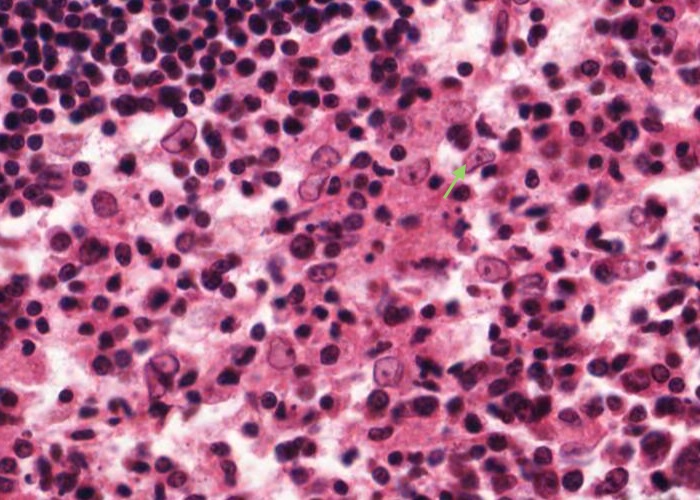
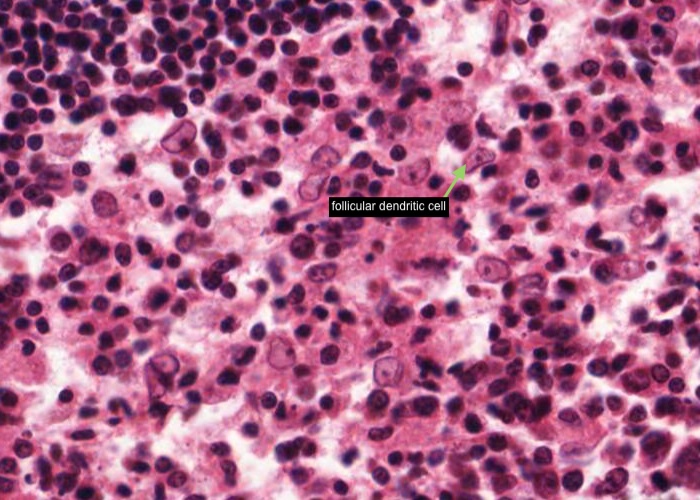
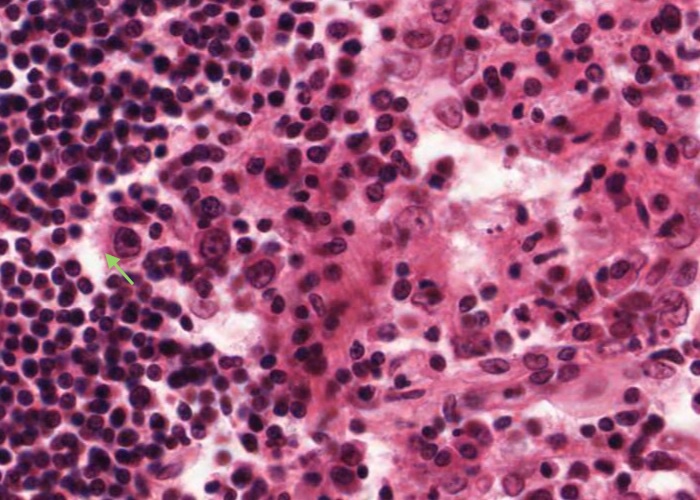
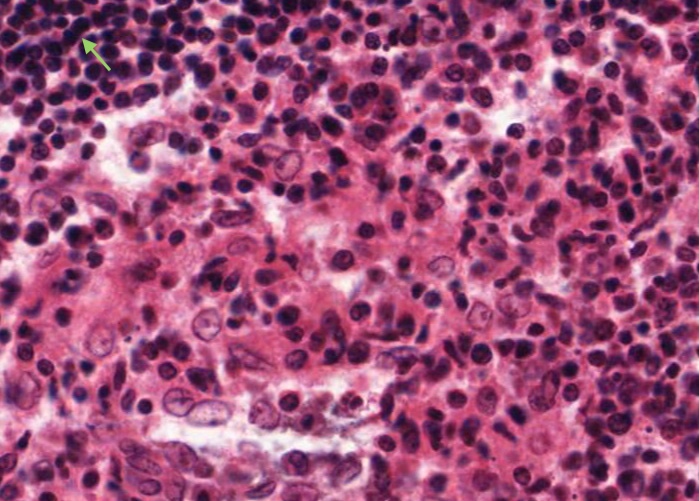
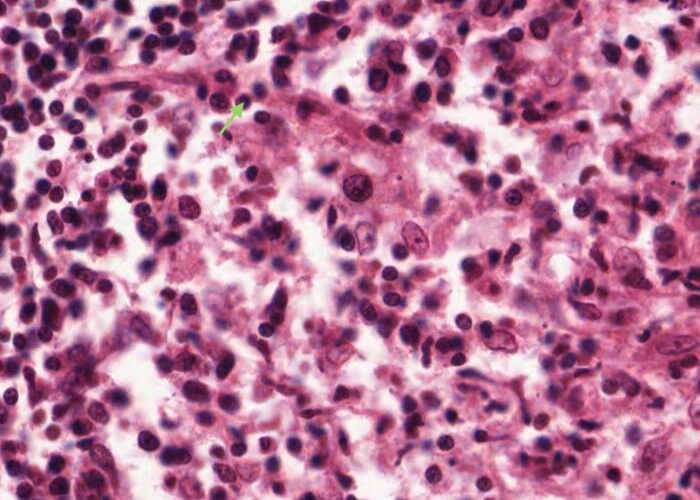
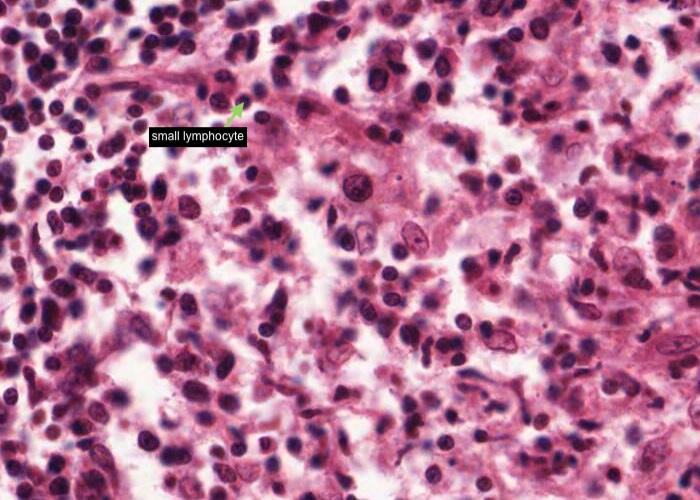
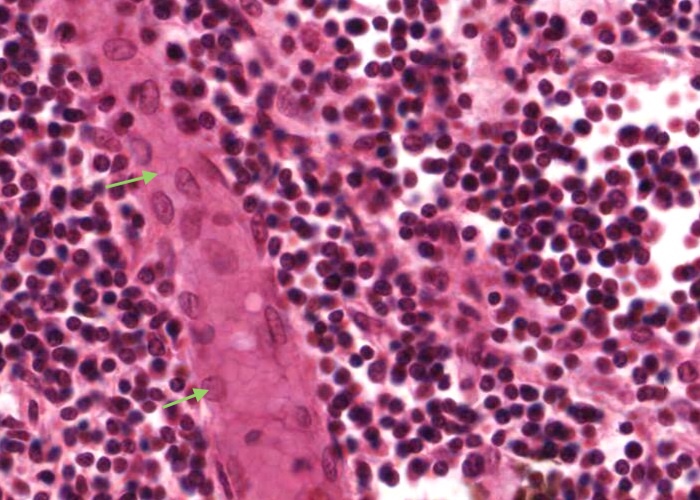
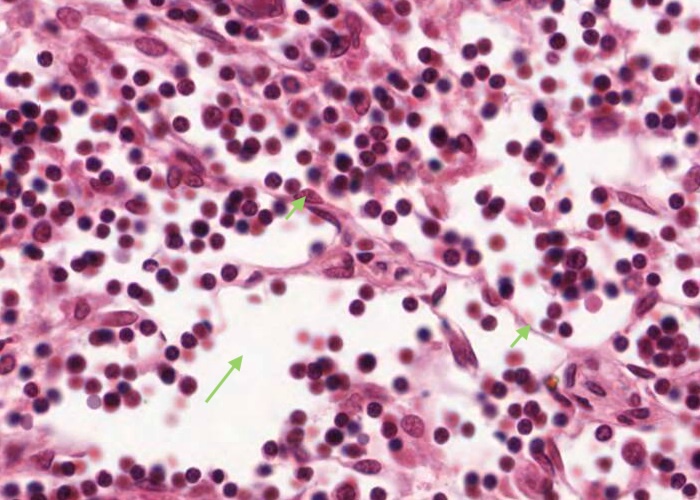
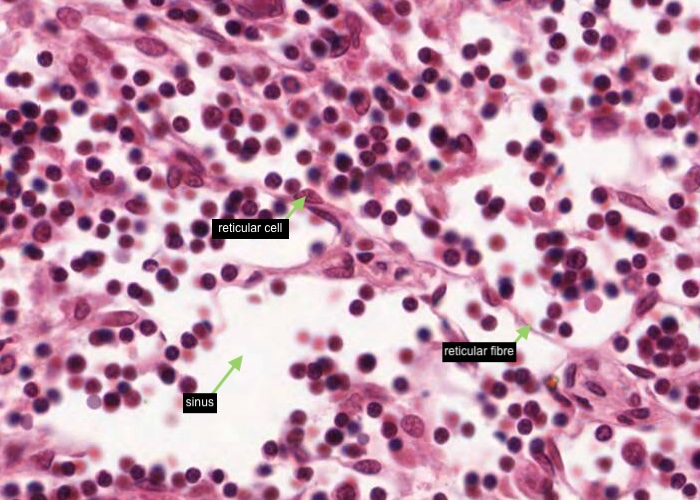
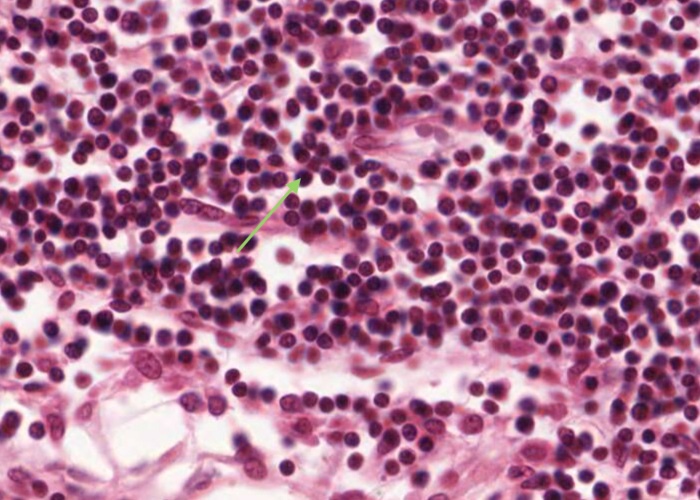

ANHB2214 Lymphatic tissue
1/64
There's no tags or description
Looks like no tags are added yet.
Name | Mastery | Learn | Test | Matching | Spaced | Call with Kai |
|---|
No analytics yet
Send a link to your students to track their progress
65 Terms


Within the mucosa of many organs such as the gut, respiratory passages, urinary and genital tract, aggregations of lymphocytes are strategically positioned to identify antigens and are called "diffuse lymphatic tissue" or mucosa associated lymphatic tissue (MALT). They are easily identified as collections of dark stained nuclei.


As well as diffuse lymphatic tissue, aggregations of lymphocytes can form a "secondary" lymphatic nodule (often called lymphatic follicles) within the mucosa of the gut, respiratory passages, urinary and genital tract, and they are characterized by having a germinal centre and a mantle zone (or corona). Details of these two components will be provided in later items.


The palatine tonsil is a patch of specialized mucosa along the pharynx. It has three components:
a stratified squamous epithelium displaying various stages of infiltration by lymphocytes.
a lamina propria choked with small lymphocytes and peppered with lymphatic nodules.
an underlying dense connective tissue.
The epithelium dips down as deep infoldings (crevices) into the underlying connective tissue of the tonsil. Each crevice, called a crypt, is the primary organizational feature of the tonsil. The irregularly shaped tonsil imaged here (and available for you to view using virtual microscopy) has been sectioned more or less parallel to the surface so that some of the epithelium-lined crypts are cut in cross section. Bacteria and other antigenic debris accumulate in them and leak antigens into the surrounding connective tissue. Numerous lymphatic nodules line the crypts, especially in children.
Observe that the tonsil rests on a sheet of dense connective tissue. The deft surgeon can dissect out an inflamed tonsil along this capsule with a minimum of fuss.


The epithelium dips down as deep infoldings (crevices) into the underlying connective tissue of the tonsil. Each of these crevices, called a crypt, is the primary organizational feature of the tonsil. Bacteria and other antigenic debris accumulate in them and leak antigens into the surrounding connective tissue.
Each lymphatic nodule lining each crypt as easy to see.


Tonsils house vast numbers of lymphocytes. These cells are drawn in from the blood through tall postcapillary venules, similar to those you will see later in the lymph node.
The lymphocytes wander throughout the mucosa waiting to be stimulated by antigens that diffuse in from the decaying debris in the crypt. Many invade the epithelium, so much so that, in some places, you have trouble recognizing the epithelium at all. At high magnification such epithelium looks like dense aggregations of lymphocytes (each with dark, circular nucleus) with the anomalous large pale nucleus (of each of the epithelial cells) scattered among them.


This tonsil has many plasma cells. A good place to look for them is right under the epithelium. Make a point of looking at a number of examples until you can recognize them by their cartwheel nucleus, their basophilic cytoplasm (far more extensive than small lymphocytes have) and possibly by their pale-stained Golgi body next to the nucleus.

The spaces between collagen fibres of the capsule happen to be other favorable places to look because plasma cells here can be seen without bunches of other cells on top of them.


Tonsilar tissue occurs on the posterior dorsum of the tongue near the junction with the anterior portions. This section of the tongue has been cut to include portions of a lingual tonsil dominating the epithelial border or dorsum of the tongue. These tonsils have the same general structure as the palatine variety - oral mucosa which will be infiltrated by lymphocytes, crypts and lymph nodules. One specialization, not shown well here, is that glands empty their secretions into the crypts of the lingual tonsil. You can just see a few profiles of a duct. This keeps them from getting infected as frequently as the palatine tonsils. It is rare to have to surgically remove infected tonsils from the tongue.


This image of the ileum shows the aggregation of lymphatic nodules known as Peyer’s patches. These are a component of the gut associated lymphatic tissue (GALT) and their function in relation to the small intestine presumably parallels that of the tonsil to the pharynx and the appendix to the colon.
Note that the corona has more lymphocytes around one side than the others. The more developed side is towards the lumen, as it also is for the appendix. It is uncertain whether or not these three lymphatic aggregations along the gastrointestinal tract have some special role in immunity beyond those of isolated nodules found throughout the mucosae of the body. They of course enable you to readily identify the ileum from other segments of the small intestine such as the duodenum and jejunum which you will learn more about in a later topic.


The appendix represents a small blind outpocketing of the large intestine. The mucosal and submucosal layers have been entirely converted into a mass of lymphoid tissue. Note the similarity in structure between the appendix and the tonsil. Both contain enormous depots of lymphoid tissue separated from a dirty, stagnant space or lumen by an epithelium infiltrated with lymphocytes. Tonsils alert the immune system to the resident bacteria in the throat. The appendix stimulates immunity to the range of bacteria that colonize the other end of the GI tract.


The mucosal layer and submucosal layer have been entirely converted into a mass of lymphoid tissue. Only the muscularis externa is a clearly recognisable typical layer of the gut wall.


Enormous depots of lymphoid tissue within the mucosa and submucosa are separated from a stagnant lumen by an epithelium infiltrated with lymphocytes.


The thymus has extremely sophisticated functions but they are not reflected in structure visible on routine histological sections. You will be able to distinguish only two classes of cells, thymocytes (T cells) and epithelial reticular cells. Examine this section grossly and note that it is divided into lobules, each with a darker-staining cortex and lighter-staining medulla.


The thymus has a connective tissue capsule with septa of connective tissue that separate the lobules of the thymus and invests them with thin seams of connective tissue. Arteries enter the thymus through the capsule and arterioles leave the septa to penetrate the parenchyma. Medullary veins penetrate the connective tissue septa and leave the thymus through the capsule.


The seams (trabeculae) of connective tissue separate the lobules of the thymus. Identify the lobule cortex and lighter-stained medulla.


Note at low/medium magnification lobules, each with a darker-staining cortex and lighter-staining medulla and invested by seams of connective tissue penetrating from the capsule.


This image shows an area of the section dominated by the darker-staining cortex. Connective tissue invests each lobule of the thymus. Many blood vessels (identified by having their lumens filled with red blood cells) are within septa of connective tissue before they divide into smaller arterioles and capillaries to enter the cortex and medulla of each lobule.
The cells are predominantly T- lymphocytes and their immediate precursors. T- lymphoblasts actively divide here. Most of the newly formed T- cells die at the hands of macrophages. Others with appropriately rearranged T- cell receptor genes escape to the capillaries at the boundary with the medulla and contribute to the circulating pool of T- cells. The only blood vessels in the cortex are capillaries. This turns out to be significant. There is a blood-thymus barrier in the cortex. It is one of these sophisticated functions that is not apparent from light microscopy.


A type I epithelioreticular cell can be seen at the boundary of the capsule and the cortex but also between the septa/trabeculae of connective tissue and the cortical parenchyma; and the adventitia of cortical blood vessels. They function as a barrier that isolates developing T-cells from the connective tissues and blood spaces of the organ.


Each type II epithelioreticular cell has a pale-stained nucleus and lies within the parenchyma of the cortex. Their cytoplasmic extensions join (via maculae adherents) with other type II cells and they compartmentalise the developing T- cells and also participate in their development.

A type III epithelioreticular cell can be seen at the boundary of the cortex and the medulla. They are similar to type 1 cells in functioning as a barrier that isolates developing T- cells between the cortex and medulla.


There are also a substantial number of macrophages in the cortex but you will not be able to distinguish them from epithelial reticular cells in this H&E preparation. If a large pale nucleus has a substantial amount of cytoplasm around it it probably belongs to a macrophage instead of an epithelial reticular cell.


Mast cells with very prominent red-stained granules in their cyoplasm are common at the boundary of the thymus cortex and medulla.


The medullary regions are paler because they have far fewer T lymphocytes (thymocytes). This makes the epithelial reticular cells easier to observe. Some of them aggregate into easily seen pink structures called Thymic or Hassall's corpuscles. The function and significance of these structures are unknown (likely they have none). They are composed of swirls of epithelial reticular cells around a keratinized or calcified core. The blood-thymus barrier is interrupted in the medulla, and here one can find blood vessels larger than capillaries. This allows T- lymphocytes to escape from the medulla into the circulation.

A type IV epithelioreticular cell can be seen at the boundary of the cortex and the medulla close to the locatioons of the type III epithelioreticular cell. Together these cells interconnect and function as a barrier that isolates developing T- cells between the cortex and medulla

A type V epithelioreticular cell is located within the medulla with similar structure (and function) to the type II cells in the cortex.

A type VI epithelioreticular cell characterise the thymic or Hassall's corpuscle. These are concentrically arranged collections of type VI epithelioreticular cells with flattening nuclei. The centre of the corpuscle may show keratinisations

All lymphocytes that enter the cortex of the thymus are not able to contact antigen because of the blood-thymus barrier - it is a physical barrier. The structures that constitute the blood-thymus barrier are endothelium lining the capillary wall (identified by the presence of a few red blood cells) and maybe a pericyte that may be also present, any macrophage in the vicinity/perivascular connective tissue and a type I epithelioreticular cell.
You can see similar components of the blood-thymus barrier around the venule in this image.
Begin by distinguishing the cortex from the medulla. Observe that each lymph nodule lies at the outer edge of the cortex. The region of the cortex near the junction with the medulla and without nodules is the paracortex (thymus-dependent region of the node). It is where most of the T cells in the node are located. The hilum is the region where blood vessels enter and leave the lymph node and where an efferent lymphatic vessel exits. The dark stained efferent lymphatic vessel is due to the vessel being packed with lymphocytes.


A small afferent (arriving) lymphatic vessel is harder to find but you may see one or two external to, or traversing, the capsule. Look especially for ones packed with lymphocytes.
With the aid of your descriptive text , assure yourself of the pathway that the lymph takes in percolating through a lymph node from the afferent to the efferent lymph vessels. It travels mainly through sinuses. In the medulla relatively open sinuses are interspersed between medullary cords packed full of cells. In examining the other lymphatic tissues and organs (spleen, tonsils, appendix), it is useful to compare their organization with that of a lymph node.
You will adequately know the histology of each lymphatic organ if you learn the following three aspects of it:
the pathway of lymph or blood through the tissue.
any special cell types of the tissue.
sources of antigen to which the tissue will be exposed.
In the case of a lymph node, antigens come in with the lymph from the overlying (perhaps infected) connective tissue.


An efferent (exiting) lymphatic vessel, packed with lymphocytes but no erythrocytes, is located in the hilus of the lymph node.


Identify the capsule of connective tissue (mostly collagen) sending a trabeculum of connective tissue into the cortex; the subcapsular sinus (mostly collapsed), and lymphatic nodule (lymphatic follicle).


This section has been stained for reticular fibers. It shows the organization of the entire lymph node well, even though the cells barely show up.
At appropriate magnification (view the section via the link below) you will be able locate, the capsule, with its underlying sinus, trabeculum, medullary cords, vessels in the hilum, lymph nodules, and even their germinal centres. All of these structures are mapped out in reticular fibres. In fact, it is the stroma - the reticular cells stretched out along these fibers - that causes the various parts of the organ to form where they do.


Carefully examine the reticular fibres at high magnification. See that they form a supporting reticulum to house wandering cells.
When you examine the histological section find a place which shows that the reticular fibers are continuous with coarse Type I collagen fibres of the trabeculae and capsule. Type I collagen fibres stain brown instead of black because they have less carbohydrate on their surface.


Each reticular cell has an oval nucleus and cytoplasm stretched out along the reticular fibre.
Also at the bottom of this image there is probably some coarse Type I collagen fibres stained brown instead of black because they have less carbohydrate on their surface.

Again in this H&E section, each reticular cell has an oval nucleus and its cytoplasm is stretched out along the reticular fibre.


Identify the capsule, an afferent lymphatic vessel, subcapsular sinus (mostly collapsed), medullary cord in the medulla.
Look at a lymphatic nodule in the cortex. Identify a germinal centre and the corona (mantle) around it.


Just under the capsule on the convex surface of the lymph node is the subcapsular sinus. It is bound by a loose network of reticular fibres and reticular cells and often has macrophages in the vicinity. The subcapsular sinus is continuous with a trabecular sinus and the medullary sinus.


The subcapsular sinus is continuous with a trabecular sinus (which is just under each trabeculum of connective tissue) and the medullary sinus.


The trabecular sinus is lined by an endothelium not to be confused with a fibroblast of the trabeculum connective tissue.


Look at the nodules in the cortex. Identify a germinal centre and the corona (mantle) around it. Most of the cells in the corona are small lymphocytes. In contrast, many of the cells in a germinal centre of the nodule have large, pale nuclei. This is why a germinal centre stains palely.

The maximal magnification is barely adequate. Scan the cortex for a germinal centre in which the cells are not jammed too heavily on top of one another.
If you see a large, pale nucleus which seems to have no cytoplasm at all around it then it is most likely a follicular dendritic cell. These cells actually have a lot of cytoplasm but it is stretched out into long arms that extend out of the plane of section. Their function is to hold antigen molecules on their surface and "present" them to lymphocytes. They are one type of antigen presenting cell. Various other cell types also present foreign or self antigens.

More rarely you will see nuclei as large as those of dendritic cells, but darker and with a discrete rim of basophilic cytoplasm. The cytoplasm will have a sharp outer perimeter. These cells are lymphoblasts. Their edges are visible because they do not have cytoplasmic arms sticking out.

Small lymphocytes dominate the corona. You can also find occasional prolymphocytes, with more, basophilic cytoplasm than small lymphocytes and with larger, paler nuclei. The supporting reticular cells have elongate nuclei. You also may come across a plasma cell or two.

Finally there are substantial numbers of small lymphocytes each with a circular, dark-stained nucleus.


The paracortex does not contain any lymphatic nodules and is mainly a site for mostly T lymphocytes to aggregate.

Lymph nodes have a blood vascular system as do most connective tissues. Small arterioles enter a lymph node at the hilum, course outwards usually along medullary trabeculae, and become capillaries that loop to the surface and back.
The capillaries collect into venules in the paracortex. These run through the medulla and drain at the hilum.
The important specializations of this vasculature are the tall postcapillary venules (TPCV), also called high endothelial venules (HEV). These vessels are lined by specialized cuboidal epithelium, look for an oval shaped nucleus (sometimes even described as columnar) instead of the usual squamous variety. They are located in the paracortex as the first segments of the venules.
Recall their role in the pathway of lymphocyte circulation. See if you can find several examples and even some sectioned transversely (see next item). If not, you will have no problem recognizing them if you go back and re-examine the section of the tonsil.


In this image, the tall postcapillary venule (TPCV), also called a high endothelial venule (HEV), is sectioned transversely. Look for an oval shaped nucleus (sometimes even described as columnar) instead of the usual squamous variety.
Some lymphocytes live for a very long time and so recirculate continuously. Their "homing behaviour" is a consequence of molecules on their cell surface interacting with complementary molecules on the endothelial cell surface of these specialised venules.


Each medullary cord is a long extension of a lymphatic nodule in the cortex and mostly contains B lymphocytes and plasma cells migrating out of the lymph node. Dilated medullary sinuses also dominate which are really just spaces for the lymph to percolate. These sinuses are interspersed by reticular fibres, reticular cells and macrophages.

The dilated medullary sinus is just a space for the lymph to percolate. Each sinus is connected to others and interspersed by reticular fibres, reticular cells (look for an elongated nucleus sitting on a reticular fibre) and macrophages.

As described in an item above, each medullary cord is a long extension of a lymphatic nodule in the cortex and mostly contains B lymphocytes and plasma cells migrating out of the lymph node. It is fairly easy to recognize a lymphocyte with a nice rounded nucleus and little, if any, cytoplasm. It is too difficult to clearly see a plasma cell - or can you?


At low magnification note the dark blue/black dots of white pulp in a background of red pulp. The irregular empty spaces are veins running in the dark red trabeculae


The capsule and trabeculae (extensions of the connective tissue into the parenchyma) are made up of dense ordinary connective tissue but containing myofibroblasts/smooth muscle with an often spiral shaped nucleus.

I

n this image of the spleen from a dog, a trabeculum happens to be composed of smooth muscle instead of ordinary dense connective tissue. The other section that you can examine is from a human and its trabeculae are of typical ordinary dense connective tissue.
These finger-like projections of connective tissue have two functions. One is to physically support the mass of splenic pulp which otherwise would have the consistency of very soft jelly. The other is to provide passage ways for the larger arteries and almost all of the veins. The trabecular arteries and veins run right down the middle of the trabeculae. Remember that the blood has been flushed from them. The veins have no wall of their own other than a sheet of endothelium. Thus, they look like large, irregular cavities in the trabeculae. Close inspection will show the flattened nucleus of the lining endothelium which identifies them as blood vessels instead of just artifactual spaces.


A trabecular artery has a more definitive structure, with a well developed tunica media. The smooth muscle of that layer is circularly arranged while that of the surrounding trabeculum runs longitudinally. Thus it is easy to distinguish between the two. The trabecular arteries also have an adventitia layer of dense connective tissue. In some places this is hard to see but in others, where the tissue has shrunk, the adventitia has pulled away from the wall of the trabeculum. The artery then appears to be floating in a hole in the trabeculum. One warning is that arteries run for a shorter distance in the trabeculae than veins. Therefore you see more sections of trabecular veins. The reason for the difference is that the arteries run for a considerable distance in the pulp as central arteries. Pulp veins are almost too short to notice. If you look around you can find places where the sinusoids seem to drain directly into trabecular veins because the pulp veins are so short.


The trabecular arteries and veins run right down the middle of the trabeculae. Remember that the veins have no wall of their own other than a sheet of endothelium. Thus, they look like large, irregular cavities in the trabeculae. Close inspection will show the flattened nuclei of the lining endothelium which identifies them as blood vessels instead of just artifactual spaces.


As mentioned earlier arteries run for a shorter distance in the trabeculae than veins. Pulp veins are almost too short to notice. If you look around you can find places where a sinusoid seems to drain directly into a trabecular vein because the pulp vein (?) is so short.


The white pulp looking like small islands of dense lymphatic tissue is always accompanied by an arteriole, the central artery. When you view the section, observe several islands of white pulp at mid magnification. They are purple because the predominant cell types are small lymphocytes with dark nuclei and scant cytoplasm.


The white pulp (dense lymphatic tissue) is always accompanied by an arteriole, the central artery (note the smooth muscle of the tunica media and the endothelium of the tunica intima). In three dimensions the white pulp has the geometry of a branching tree surrounding branching central arteries. These tiny arteries are called "central arteries" because they run in the interior of the elusive splenic lobule, not because they run down the middle of the white pulp. Typically central arteries are off to one side in their area of white pulp as you saw in the previous item.


Actually, the white pulp can be thought of as the tunica adventitia of these arteries, but composed of lymphocyte-laden reticular tissue instead of the usual ordinary dense connective tissue. This sheath of T lymphocytes is called the periarterial lymphatic sheath (PALS).


Occasional a lymphatic nodule will develop in the white pulp. They are especially abundant in children and in people with a blood-borne disease.
If the section goes through a nodule such as you see here, the area of white pulp looks much larger and denser. You may even find a germinal centre in some sections. It is important to realize, however, that white pulp is more than just nodules. Note that two stated outcomes of this topic are to know the locations of the PALS and the marginal zone.


The red pulp is composed of a lattice of reticular cells infiltrated by enormous quantities of blood cells. Many venous sinusoids traverse it. Each venous sinusoid is expanded and empty on this section because this tissue was deliberately perfused with saline before it was fixed. The areas of tissue between sinusoids are called "cords" (a poor term), so that red pulp is a mixture of cords and sinusoids. The sinusoids are large, irregular, elongated structures.


Examine the reticular cells of the cords. Find an area of red pulp that has been well flushed of red blood cells. Some areas along the connective tissue trabeculae are especially free of blood cells. The strings of cytoplasm that you see are arms of reticular cells stretched out along invisible reticular fibers to form a meshwork. Find the nucleus of a reticular cell. Reticular cells in the right orientation will show a thin coat of pale, bluish cytoplasm surrounding their nuclei and extending out into long arms.
Next look for macrophages that are ingesting red blood cells. They are easy to spot because the engulfed erythrocytes are bright orange/yellow. You will find many alongside trabeculae.
Now turn to the free cells wandering through the reticulum. Again, look in places in the cords where the cells are not too crowded. A small lymphocyte and plasma cell are the most abundant type. The plasma cell will have a round nucleus about the size of that of a lymphocyte, maybe surrounded by a substantial amount of basophilic cytoplasm and/or a clear region where the Golgi complex is located. The grains of chromatin in their nuclei are more distinct and contrasty than is the case with lymphocytes. Find and examine at least half a dozen plasma cells. Monocytes are recognized by their small bean-shaped nuclei but are not easy to find. You would have to scan at maximal magnification to pick them out. During this scanning neutrophils are a pleasure to come across. Their complex nuclei make them unmistakable. Even more pleasurable is to come across a megakaryocyte! That's right, these are to be found in the spleen of the dog, although not the human.


Each sinusoid is lined with specialized endothelial cells that are cigar shaped instead of flat. In cross section the endothelial cell nucleus looks round and bulges into the lumen of the sinusoid. Where the section misses the nucleus the cell looks like a tiny bleb at the edge of the sinusoid.
The endothelial cells do not form a continuous sheet - slits between them allow blood cells to percolate in and out.


In cross section the endothelial cell nuclei look round and bulge into the lumen of the sinusoid. The nuclei of the endothelial cells look elongate when sectioned longitudinally. The cells are held in place by reticular fibres wrapped circumferentially around the outside of the sinusoid.


You will recall that the internal organization of reticular tissues are reflected in, and were programmed to be where they are, by the reticular cells anchored to reticular fibres. Snoop around at those fibers surrounding each sinusoid, and in the splenic cords, white pulp and central arteries. Pretty neat, eh, especially the parallel fibers banding around the sinusoid.